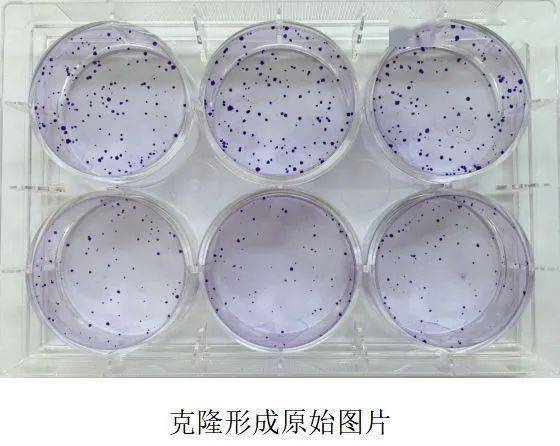

產(chǎn)品中心Cell Resources
聯(lián)系我們CONTACT US
 18225607483
18225607483
24小時服務(wù)熱線 355185756@qq.com銷售郵箱
355185756@qq.com銷售郵箱
產(chǎn)品詳情
實驗原理
細(xì)胞克隆形成率即細(xì)胞接種存活率,表示接種細(xì)胞后貼壁的細(xì)胞成活并形成克隆的數(shù)量。貼壁后的細(xì)胞不一定每個都能增殖和形成克隆,而形成克隆的細(xì)胞必為貼壁和有增殖活力的細(xì)胞。克隆形成率反映細(xì)胞群體依賴性和增殖能力兩個重要性狀。
基本步驟
1.取對數(shù)生長期的各組細(xì)胞,分別用0.25%胰蛋白酶消化并吹打成單個細(xì)胞,并把細(xì)胞懸浮在10%胎牛血清的DMEM培養(yǎng)液中備用。
2.將細(xì)胞懸液作梯度倍數(shù)稀釋,每組細(xì)胞分別以每皿50、100、200個細(xì)胞的梯度密度分別接種含10mL 37℃預(yù)溫培養(yǎng)液的皿中,并輕輕轉(zhuǎn)動,使細(xì)胞分散均勻。置37℃ 5% CO2及飽和濕度的細(xì)胞培養(yǎng)箱中培養(yǎng)2~3周。
3.經(jīng)常觀察,當(dāng)培養(yǎng)皿中出現(xiàn)肉眼可見的克隆時,終止培養(yǎng)。棄去上清液,用PBS小心浸洗2次。加4%多聚甲醛固定細(xì)胞5mL固定15分鐘。然后去固定液,加適量GIMSA應(yīng)用染色液染10~30分鐘,然后用流水緩慢洗去染色液,空氣干燥。
4.將平皿倒置并疊加一張帶網(wǎng)格的透明膠片,用肉眼直接計數(shù)克隆,或在顯微鏡(低倍鏡)計數(shù)大于10個細(xì)胞的克隆數(shù)。最后計算克隆形成率。克隆形成率 =(克隆數(shù)/接種細(xì)胞數(shù))×100%
平板克隆形成試驗方法簡單,適用于貼壁生長的細(xì)胞。適宜底物為玻璃的、塑料瓶皿。試驗成功的關(guān)鍵是細(xì)胞懸液的制備和接種密度。細(xì)胞一定要分散得好,不能有細(xì)胞團,接種密度不能過大。